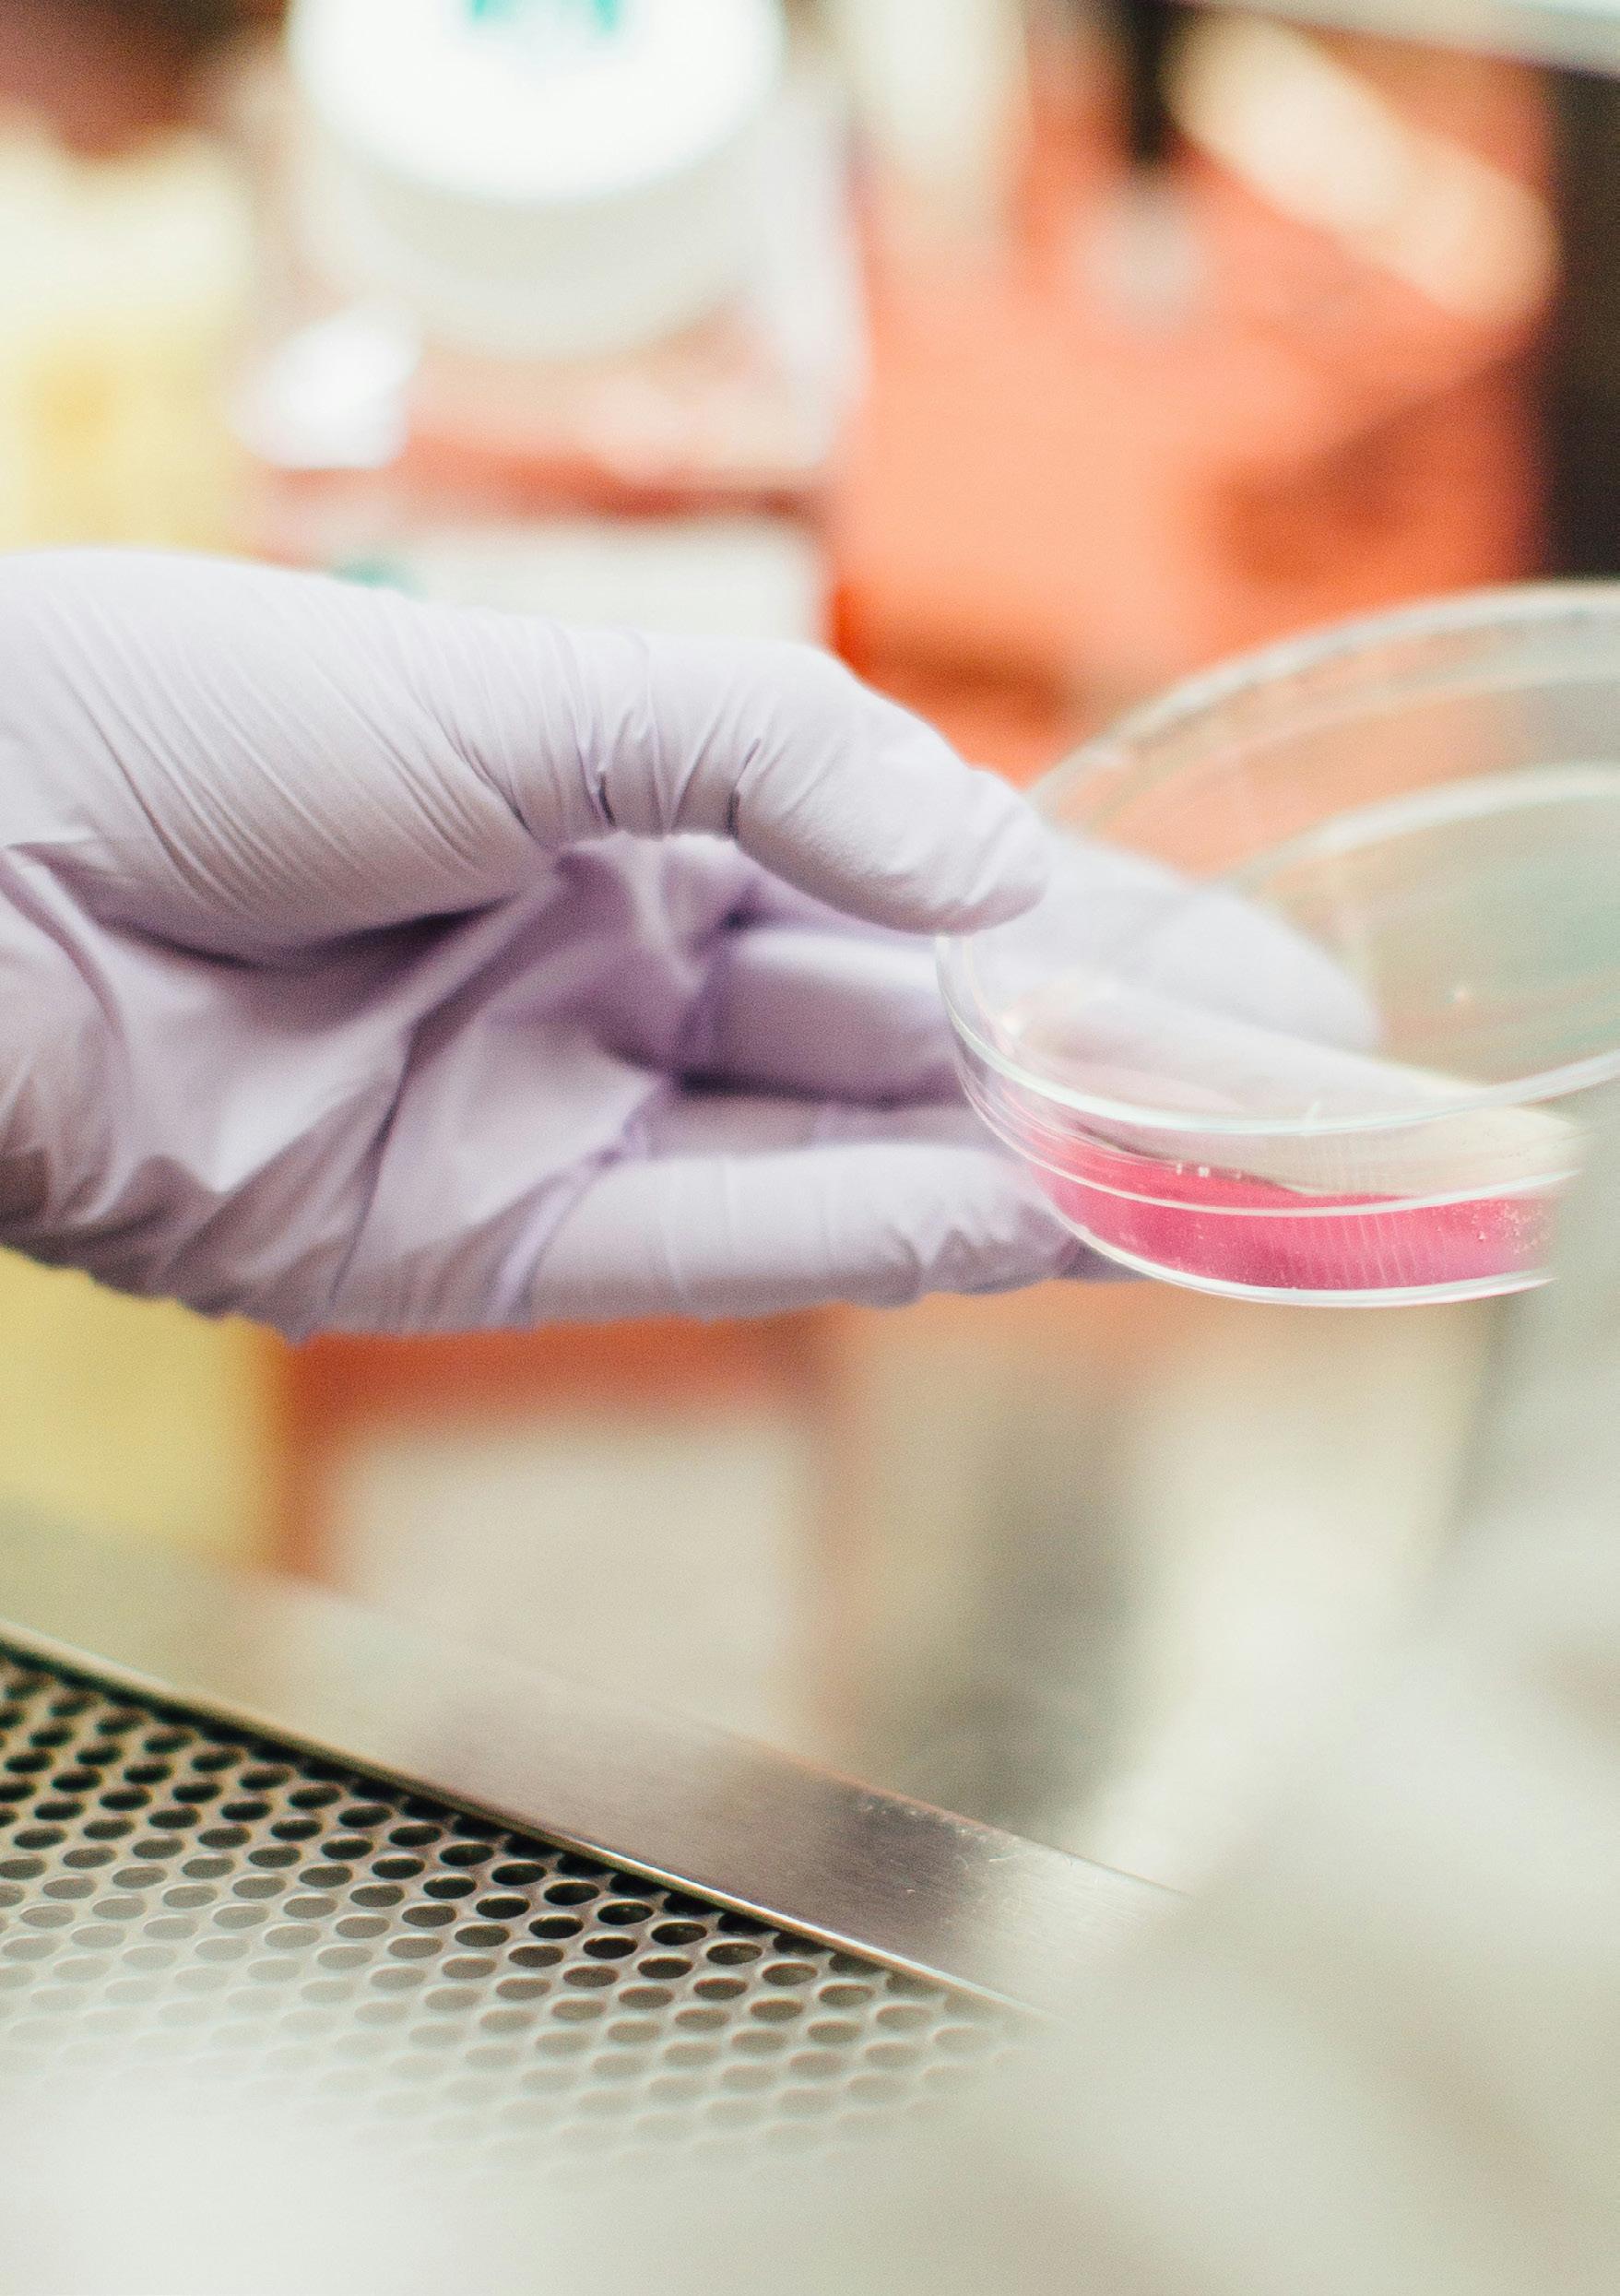

![]()













Some of our fundraisers


I begin this introduction to the 30th edition of Believe magazine with a heartfelt thank you for your support in raising awareness and money for Brain Tumour Research. Our financial year ending in June 2025 was exceptional – more than £8.6 million was raised to help find a cure. It is only thanks to your fundraising and donations that our Centres of Excellence can continue their vital work. In this magazine you’ll read how that money is making a difference, including a transformative £2.5 million funding commitment for our Centre at Queen Mary University of London, as well as new studies which further our understanding of meningioma and glioblastoma, and how our Funded Initiatives are changing the landscape.
This summer saw us achieve a collaborative milestone with the Rare Cancers Bill passing through the House of Commons. Our Charity, our campaigners, and indeed many of you reading this magazine, have been key players in developing this Bill with Scott Arthur MP and, as I write this foreword, it has passed its third reading in the House of Commons and first reading in the House of Lords. This Bill has the potential to transform the lives of those diagnosed with rare cancers, including brain tumours. I’m immensely proud of the change we are driving in Westminster and across the devolved nations. You can read more on pages 28-31.
Dr Scott Arthur MP and Dame Siobhain McDonagh, Chair of the All-Party Parliamentary Group on Brain Tumours







Our Closer to a Cure – 15 Years of Impact gala dinner during Brain Tumour Awareness Month was a unique opportunity to celebrate the journey we’ve been on since the Charity was launched in 2009, the families whose support has been crucial, the research projects we have funded, the campaigning progress we have influenced and the game-changing collaborations we have established – all with one singular vision: to find a cure for all types of brain tumours.

The impact the Charity has made is in no small part thanks to the incredible legacy of our Co-founder and former Chief Executive Sue Farrington Smith MBE.
Sue’s family was devastated by the loss of her niece, Ali, to a brain stem glioma (commonly known as DIPG) three weeks before her eighth birthday in 2001. Determined that Ali’s life would not be in vain, they launched the Charity , the first step on the journey to establishing Brain Tumour Research and impacting the lives of thousands across


© Owen B Photo
Under Sue’s leadership, we established five Centres of Excellence and became the leading voice of the brain tumour community in parliament and across the media. In 2023, Sue retired as Chief Executive following her diagnosis with low-grade abdominal cancer. She has now decided to step back from her role as Trustee to dedicate more time to her family. We are indebted to Sue, her tenacity and dedication, and her tireless personal fundraising which continues to this day. As she takes on a new mantle as Ambassador (read more on pages 16-17), we remain committed to continuing the momentum she has built in uncovering the breakthroughs patients and families so desperately need.
So, as we look forward to a busy end to 2025, I urge you to continue to support us however you can. Please join our fundraising campaigns and challenges, set up a regular gift or leave a legacy, campaign with us, or share your story – any way you can get involved will help us get closer to delivering much-needed hope to everyone affected by this devastating disease.
Together we will find a cure
Dan Knowles CEO

Scientists at our Brain Tumour Research Centre of Excellence at the University of Plymouth continue their persistent pursuit of a cure.
In a recent research project, the team discovered how the genetic makeup of meningioma – the most common type of brain tumour in adults –shapes the behaviour of immune cells.
Immunotherapy, which harnesses the body’s immune system to fight cancer, has been inconsistent in treating meningioma. To understand why, researchers used pioneering 3D models to mimic how immune cells interact with tumours, and found clear differences in immune cells between more aggressive and less aggressive tumours. They showed that a specific immune cell type is more prevalent in meningiomas with certain genetic mutations or molecular profiles. These cells appear to accelerate tumour growth.

to continue to fund life-saving research
This research not only lays the foundation for new immunotherapy strategies but marks a critical step towards personalised treatment approaches for meningioma.
In another study, Plymouth scientists identified a protein that drives growth of certain meningioma cells. By blocking this protein in laboratory experiments, the researchers were able to slow – and in some cases completely stop – tumour cell growth. This raises hope of the development of less invasive treatments for patients with meningioma, who currently rely on surgery and radiotherapy.
Progress like this is made possible by the long-term funding and secure environment provided by our Centres of Excellence, which allows researchers to progress in their field. A member of our Plymouth Centre research team, Dr Sarah Kingdon, has done just this, having recently been awarded Scotland’s first dedicated Neuro-oncology Fellowship.
The inaugural Scottish Tessa Jowell Fellowship is co-funded by the Beatson Cancer Charity and NHS Lothian Charity and run in partnership with the Tessa Jowell Brain Cancer Mission and The Chief Scientist Office. It will take place at our Scottish Brain Tumour Research Centre of Excellence, jointly hosted by the Edinburgh Centre for Neuro-oncology and the Beatson West of Scotland Cancer Centre. The 12-month Fellowship will provide Dr Kingdon with the research skills needed to, in time, lead high-impact clinical trials, allowing us to progress game-changing discoveries such as those happening at Plymouth. This Fellowship also represents a valuable opportunity for our researchers to work together across different Centres of Excellence. Movement between Centres fosters the exchange of knowledge and skills, crucial for advancing research and improving outcomes for brain tumour patients.





Our vital vision to find a cure is gathering momentum across our entire network of Centres of Excellence, with Queen Mary University of London no exception.
In May, researchers there revealed results of a study that could prove game-changing for the treatment of recurrent glioblastoma tumours.
This most aggressive form of brain tumour is notoriously difficult to treat, and almost always returns – and when it does, the recurrent tumour is often markedly different in its make-up to the original; therapies that were previously effective, now have little or no impact.
At Queen Mary, our researchers used a pioneering new technique to explore why.
Innovatively mimicking the human treatment process in implanted human glioblastoma models, they were able to accurately replicate how glioblastoma tumours return and evolve after treatment. This allowed them to identify a specific type of cell that becomes more prevalent when glioblastoma recurs. These cells, which display tiny hair-like structures called cilia, are more
resistant to treatment. But the team found that targeting these ciliated cells with a readily available over-the-counter medication, commonly used for threadworm, could make them more sensitive to chemotherapy.
This innovative approach opens pathways to personalised medicine, allowing researchers to identify patient-specific vulnerabilities, improving the chances of successful treatments when first-line therapy has failed.
Pioneering advances like this are made possible only by our incredible supporters, and earlier this year your generosity enabled us to award Queen Mary a £2.5 million research funding boost.
This will enable scientists to continue to develop personalised treatments for glioblastoma, and to develop gentler, more effective therapies for childhood brain tumours.

Centre Director, Professor Silvia Marino, said: “High-grade brain tumours are challenging. We are thrilled to receive this funding, at a time when our basic research is closer than ever to clinical translation.”


Your support will allow us to continue to fund the game-changing work of our researchers. Visit our website to set up a regular donation or give a one-off amount: www.braintumourresearch.org/donate
a network of seven sustainable Centres of Excellence across the UK to find a cure more children and adults under the age of 40 than any other cancer

It’s been a year since we announced the Brain Tumour Research Scottish Centre of Excellence and we’re getting closer to changing the story for brain tumour patients in Scotland.





The Centre, which officially launched in January, is a game-changing collaboration between Brain Tumour Research and Beatson Cancer Charity. Based at the Universities of Edinburgh and Glasgow, it is dedicated to advancing the development of new treatments for glioblastoma, with the aim of producing the evidence required to rapidly progress these treatments into clinical trials for patients in Scotland and beyond.

Its first year has seen our fifth Centre recruiting talented PhD and post-doctoral researchers in order to establish its team of multidisciplinary scientists – the largest group focusing on glioblastoma in the UK – which will bridge the gap between promising new discoveries and patient benefit.
But bridging that gap costs money and it is only thanks to our dedicated supporters that we have been able to commit to investing £2.4 million over five years to fund this vital research.
Supporters such as Don and Rachel McKie who, with the support of family and friends, have raised more than £58,000 to date, inspired by their son, Graham, who died of glioblastoma in 2006, aged 32.


This summer, Don and Rachel’s incredible fundraising efforts received royal recognition when they attended the prestigious King’s Garden Party at the Palace of Holyroodhouse. Their invitation was the result of a nomination by Ian Dickson BEM, a long-time friend and co-founder of Beatson Cancer Charity.
“Meeting the King and shaking his hand was a real ‘pinch me’ moment. When Rachel shared a little of Graham’s story and our fundraising, he paused, looked at us and said, ‘That’s hard to bear.’ It was a moment we’ll never forget,” Don said.
The King also wished the couple and Brain Tumour Research well in their efforts.
Don, who attended the launch of our Scottish Centre with Rachel, added:
The generosity of our amazing supporters has raised an incredible total to fund our Scottish Centre so far.
To support the research taking place here and across our network of Centres, please donate what you can today.
Every contribution makes a real difference: www.braintumourresearch.org/ donate or scan the QR code
“The opening of the Scottish Brain Tumour Research Centre of Excellence has brought us renewed purpose. Knowing that research is finally being done here in Scotland, that glioblastoma is getting the urgent attention it so desperately needs, is deeply meaningful to us. It gives us hope for a day when no family will have to endure what we did.”


We’ve shared a raft of exciting research updates from the laboratory, and we’re proud to play a role in supporting the pioneering technological advances that are being made in therapeutics, too.
Through the Brain Tumour Research Novel Therapeutics Accelerator (BTR-NTA) programme – which is funded by Brain Tumour Research and delivered in partnership with the Tessa Jowell Brain Cancer Mission (TJBCM) – research groups that have a new therapeutic device or idea for brain tumour treatment can apply to have their research robustly reviewed by academic, clinical, patient and industry experts.
In May, QV Bioelectronics (QV), a participant in the BTR-NTA programme, received a game-changing funding boost of £1.26 million from Innovate UK’s Biomedical Catalyst Programme. This will help facilitate the first in-human trial of its implanted device, GRACE
GRACE (Glioma Resection Advanced Cavity Electric Field Therapy) is designed to deliver electric field therapy directly to the tumour margins, disrupting cancer cell division whilst preserving healthy tissue, with the goal of improving patient outcomes and enhancing quality of life.
Main image: QV Bioelectronics’ GRACE implant
Inset: The device could improve patient outcomes
We look forward to seeing how QV’s technology translates into tangible results for patients


At our Brain Tumour Research Centre of Excellence at Imperial College London, significant advances are also being made in understanding how glioblastoma brain tumours respond to radiotherapy.
In a study published in May in the journal Cancers, researchers used advanced imaging techniques to analyse MRI scans to extract detailed information unseen by the human eye – an area of research known as radiomics.
The research project, led by Dr Nicoleta Baxan, was conducted under the direction of Dr Nelofer Syed within her research group. The team discovered that specific radiomic features enabled them to predict how a tumour might respond to radiotherapy. They demonstrated that radiomics can measure subtle changes in the tumour’s structure and function, offering the possibility of using it as a virtual ‘biopsy.’ This approach could allow clinicians to monitor tumour response without invasive procedures, guiding treatment decisions more effectively.


Glioblastoma is well known for its poor prognosis and limited treatment options, so this study marks a significant turning point, which may lead to more personalised and effective treatment strategies and to the development and acceleration of brand-new therapies.
Discover more highlights from our 15 years of pioneering research in our Impact Report: www.braintumourresearch.org/ impact-report



We were honoured to work with our incredible Ambassador Sam Suriakumar to produce a poignant and impassioned film to mark his recent 40th birthday, on 26th July.
Sam was diagnosed with a glioma in 2020 after suffering a seizure on his commute home from work. With a poor prognosis from his oncologist, Sam – who is married to Sindhu and has two daughters, Avaana, 10, and Arya, eight –said: “I didn’t think I’d get to see my 40th; that’s the crude reality of living with a brain tumour.
“When I was first diagnosed, I didn’t even think I’d see the end of the week. Forty was always a big benchmark number because of the poor survival statistics for people with brain tumours, so getting to celebrate it has been a massive dream for me.”


Sam underwent a course of radiotherapy and chemotherapy, then set about his awarenessraising mission. He became an Ambassador for Brain Tumour Research in 2023, joining us for multiple fundraising campaigns, including Wear A Hat Day and Walk of Hope. He ran the 2023 London Marathon on our behalf and helped us to deliver an 80,000-strong petition to Downing Street, calling on the Government to increase investment into researching the disease, bringing hope to future patients and their families.

Running the London Marathon for us in 2023
he sets out to spread this same message of hope and positivity.
With his trademark passion, Sam says: “Hope for a brain tumour patient means stable. Personalised treatments. Better understanding of genomics. Clinical trials. Research.”
In working with us on the film, Sam is taking us one step closer to achieving all these things.

Sam now has check-up scans every six months, with his most recent in May being stable, and credits optimism and the support of the brain tumour community for carrying him through. In the film,

“I want us to keep supporting each other in the brain tumour community and to not lose hope,” says Sam. “It’s not a club you want to be part of but, once you are, we really look after each other with care and kindness. I’m calling on the Government to not forget us; to hear the needs of this community and be active in supporting that.”
Watch Sam’s film on our YouTube channel and subscribe for more inspiring content www.youtube.com/@ braintumourresearch

An Olympian, a renowned actor and a trailblazing champion of the brain tumour community have joined the cohort of high-profile supporters backing our fight against the disease.

Having dedicated two decades of her life to the cause, our Co-founder and former Chief Executive, Sue Farrington Smith MBE has stepped down as Trustee and taken on the role of Ambassador.
Sue and her family were thrust into the brain tumour arena when her beloved niece, Ali, was diagnosed with an incurable brain stem glioma (now often known as a DIPG). They lost her just 10 months later, in June 2001, aged seven. Discovering how bleak the prognosis was for Ali, and so many other children, was the catalyst for Sue’s ground-breaking journey to change the landscape for everyone diagnosed with this devastating disease.
With more time now to dedicate to her family, Sue is also devoting her energies to her new role as Ambassador.
“I am very proud of all that we have achieved at Brain Tumour Research. My passion will not wane – I will always be Co-founder and will continue to support the next era of the Charity’s growth as an Ambassador and activist, as well as attend events, fundraise and donate,” Sue said.


Joining Sue as Ambassador is two-time Olympic bronze medallist Sam Reardon. He pledged his support after losing his mum, Marilyn, to a glioblastoma in 2019.
“I was 14 when Mum was diagnosed, and it was heartbreaking to realise she wouldn’t be there for all the key milestones in my life – growing up, getting married, having kids,” said Sam who, after a storming performance in the 4 x 400m mixed and men’s relays at the 2024 Paris Olympics, carried a photo of Marilyn onto the podium to collect his medals.
Hoping to help speed up the journey to a cure, Sam has already set up several fundraising events, including a charity football match, bike rides and mountain hikes, and supported Wear A Hat Day.
Actor Charles Dale, – best known for his 10-year portrayal of Big Mac in Casualty – said he was “deeply honoured” to become an Ambassador, having witnessed the devastating impact of this disease.
Charles is good friends with fellow Ambassador and actor Craig Russell, who was diagnosed with


a meningioma in 2023. He was also a close friend to Coronation Street star Bill Tarmey, whose son Carl died of a brain tumour, and was acquainted with writer and poet Benjamin Zephaniah, who died of the disease in 2023.
Inspired by Shaun Griffiths, a life-long friend who died as a result of a brain injury, in May, Charles embarked on a month-long fundraising motorcycle ride across England and Wales. Visiting 100 motorbike cafes and joined by some famous faces, including Si King of The Hairy Bikers, Charles has raised more than £6,500 so far for Brain Tumour Research and brain injury association, Headway, with more money to come.
We look forward to working closely with our new Ambassadors to raise awareness and funds to find a cure for brain tumours.


Read more about how our Patrons, Ambassadors and Celebrity Supporters help us: www.braintumourresearch.org/patrons




We celebrated our most memorable Brain Tumour Awareness Month to date in March, banging the drum for better outcomes for patients and their families.
Our show of strength and solidarity was sent around the world on a wave of light, as supporters lit candles and posted messages of remembrance on social media, as part of our #ShineALight campaign.
From presenters to Patrons, singers to sports stars, celebrities shared our message with their thousands of followers to extend our reach.
Among those who stood in support were TV personalities Piers Morgan and Davina McCall, authors Sophie Kinsella and Adam Kay, and musicians Suzi Quatro and Sharleen Spiteri, along with Kelsey Parker, the wife of Tom Parker – singer of The Wanted – who lost his life to a brain tumour.
Singer-songwriters Rick Astley and Joan Armatrading CBE posted their pleas, joined by Qian Zephaniah, the wife of poet and activist Benjamin Zephaniah, also tragically taken by brain cancer.
Stars of both the screen and the playing field united, with cricketer Kirstie Gordon, footballer Michael Mols, Coronation Street actor Simon Gregson and BBC Scotland broadcaster Glenn Campbell joining our fight. Also supporting our campaign were actress and model Cressida Bonas, comedian Arabella Weir and TV star Dame Floella Benjamin.
Leading the charge were our Patrons Sarah Beeny, Alfie Boe, Theo Burrell, Danny Clarke and Pete Waterman OBE, and our Ambassadors Abi Feltham, Craig Russell and Sam Suriakumar.







Mid-month, our Patrons and Ambassadors, including Caprice Bourret, put on a show of support once more, joining us at a gala dinner, held at The Dorchester Hotel, London. The evening was a celebration of all we have achieved as a Charity since our inception, as we launched our incredible Impact Report: Closer to a Cure. The pioneering progress we’ve made was presented in a powerful film narrated by broadcaster Sarah Beeny, rousing the room of 300 celebrities and supporters, including presenter Johnny Vaughan and actress Dame Sheila Hancock CBE.


Brain Tumour Awareness Month closed with our flagship fundraiser Wear A Hat Day, with supporters also lighting up buildings across the land in our signature pink and yellow colours. London’s King Cross, Liverpool’s Lime Street and Leeds Railway Stations were among the landmarks set aglow as part of our Light up the UK campaign, ending another month to remember in the march towards a cure.
Theo Burrell gave an impassioned speech about living with a glioblastoma, with Alfie Boe putting on an exclusive musical performance.
Alfie invited guests to bid on tickets to his upcoming concert with Michael Ball, which – alongside pledged donations throughout the night – contributed to an incredible fundraising total of more than £30,000.






To receive all our latest updates straight to your inbox, subscribe to receive our Weekly Newsletter: www.braintumourresearch.org/subscribe

Pulling on your trainers to pound the pavements or take to the trails takes a special kind of motivation, and when you join Brain Tumour Research in the race to find a cure, you’ll find all the incentive you’ll need. Our running events are proving ever popular as supporters step up to fund research and raise awareness. Here are just a few of the brilliant races you can get involved with this year…
Brighton Half Marathon 1st March
Snake your way through this vibrant city and along its iconic seafront at one of the largest running events in the South East. This race is flat, fast, and a fantastic way to help us forward our research aims.
Bath Half Marathon 15th March
Soak up the historic World Heritage City of Bath at one of the most established road races in the country. This event has an electric atmosphere that will match your motivation as you power along to help provide hope for countless families.
Paris Marathon 12th April
Traverse the French capital’s most famous avenues and plazas. Setting off from the Arc de Triomphe and taking in views of Notre-Dame and the Eiffel Tower, you’re sure to find your raison d’etre as you race to change the lives of brain tumour patients and their families.
Select your favourites and join in the fun!






Have you got a place in this iconic event?
Run for Brain Tumour Research and help us get closer to a cure.

HELP US
Jake Martens ran as part of our team in the 2025 London Marathon and said: “I can honestly say running the London Marathon 2025 for Brain Tumour Research was one of my most fulfilling experiences. The communication, instructions and general support was amazing, which is really pleasing when doing something for a cause you’re so close to.” to continue to fund life-saving research





Experience a little northern soul and join our team to race through buzzing Manchester. As you fly along this fast and friendly route, you’ll experience the feelgood boost of knowing you’re bringing hope to families and driving breakthroughs that are urgently needed.
Great Bristol Run 10th May
Step up for Bristol’s super-scenic 10km and half marathon, where inspiring history and an edgy, urban cityscape collide. Make the miles matter and run for Brain Tumour Research, to help bring funding to the underfunded.
Edinburgh Marathon 23rd May


Take on one of the UK’s fastest marathon courses around Scotland’s capital city, while supporting a cause that saves lives. Each step you take along this flat, scenic route will help fund essential research for Brain Tumour Research
Remember, you can choose to support Brain Tumour Research no matter what running or challenge event you’re taking part in. Whether you’re looking to join our team with one of our charity places, or you’ve secured your own place in an event, you can fundraise to forward our cause.
Email: fundraising@braintumourresearch.org and one of our Community Fundraisers will be in touch to offer their support.
Feeling inspired?
You’ll find plenty more challenges to choose from at: www.braintumourresearch.org/ collections/events or simply scan the QR code


Why not sign up for one today?
Don’t forget to keep an eye out, as new challenges are added regularly.

José Maria Mendes de Abreu lost his son, Chevy, to an astrocytoma, aged 34. Here, he shares how fundraising has helped him step forward into the future:
“My son, Chevy, was the picture of health. He loved the discipline of the gym and the freedom of the outdoors, his camera always in his hand. He had a smile that everyone talked about. He was just so full of life. And then, one day, a diagnosis of a brain tumour shattered everything.
The devastation was… devastating. But Chevy built a barrier of hope around himself; when asked, he didn’t want to know his prognosis. He had a strong belief that he would be cured, and his focus was already on others. That was my son.
During this journey, his brother bought him Fairy Tale by Stephen King. Reading it to him became our ritual; we would escape into another world, one without pain or tumours. When the news came that the tumour had progressed to stage 4, the escape was gone – but the hope still remained.
On 6th April 2024, however, Chevy’s journey ended. It was peaceful. No struggle. Just a profound, terrible, deafening silence.
After that, you go into a strange automatic mode. You just do the things. Call the people.
We are fundraising to create a network of seven sustainable UK Research Centres of Excellence
Sign the forms. Past the funeral, the silence gets even louder. The world doesn’t stop, but yours has. Friends don’t know what to say –so they say nothing.
Chevy believed in Brain Tumour Research and wanted to do everything he could for the Charity. Together with family, we joined the Walk of Hope, and even in a wheelchair, he was so proud to be there, raising funds. His legacy became my mission.
I used to be a runner, but when Chevy passed, I couldn’t find the will. Then I saw the 676.2-miles Route to Research challenge online. Without a second thought, I registered. Just clicking that button, before taking a single step, felt like the first act of defiance against the paralysis of my grief.

In the darkness of my sorrow, getting out of the house to walk was a daily struggle. But the challenge gave me a reason. It forced me back into the world, onto the paths and roads. It gave me a way to take all the restless, painful energy of loss and turn it into forward motion.
For anyone reading this who feels lost in that same fog, please know that taking on a challenge like this isn’t about forgetting; it’s about finding a new way to remember. Every pound raised, every mile walked, is a continuation of Chevy’s life and our shared belief that one day, no family will have to endure this. And that hope is the greatest comfort of all.”


Chevy during radiotherapy treatment
If you have been inspired by Chevy’s story, please consider setting up a regular donation. Regular gifts give us the confidence to continue to invest in sustainable, long-term research which is essential to improve treatments and, ultimately, find a cure for brain tumours. Find out more: www.braintumourresearch.org/ donate-now


Our supporters’ fundraising efforts never fail to impress us. The creative ways our committed community finds to raise money and increase awareness are essential in enabling us to continue our work to fund, and campaign for, vital research into brain tumours.



Jonathan Ingram was first diagnosed with a meningioma in 2000. Following successful surgery, he was diagnosed with a second tumour in 2015. Thankfully, it remains stable.
Despite living with side effects, Jonathan pedalled an epic 200km as part of our 200k in May challenge, raising more than £1,300 along the way and inspiring others with his message of hope.
“You can’t let a diagnosis stop you. You might need to slow your pace but never stop,” he said.



Having grown his hair for eight years, teenager Heston Holbrook lopped 16 inches off his locks to raise money, inspired by his uncle Steve Holbrook, who passed away from a glioblastoma in 2016.
Of his new cropped barnet, Heston said:
“It felt strange at first, but I’m really happy I did it. I wanted to do something for my uncle and help people at the same time.”
His fundraising chop was stylish and effective, adding more than £1,200 to the near £70,000 raised by family and friends in Steve’s memory.

Brain tumours are indiscriminate; they can affect anyone at any age to continue to fund life-saving research HELP US



College student Holly Bailey chose to honour her nana, Patricia Ann Taylor, by illustrating and publishing a short story Patricia had written shortly before her death from a secondary brain tumour. Holly has since released the sweet children’s book Charlie Crow Goes to Mexico and is donating proceeds from its sales to Brain Tumour Research
She said: “If this book can help in some small way by raising money and getting people talking, then I’ll feel like we’ve done something worthwhile. It’s about turning loss into hope.”
From inspiring illustrations to hopeful harmonies, Sing Like You Mean It choir hit all the right notes with its cover of James Bay’s hit single Hold Back the River. It has raised close to £2,000.
Shockingly, 17 of the 46 singers in the choir have been affected by the disease, including Emma Alford, who joined the group last year following the death of her mum, Sue Kidd MBE.
Emma said: “Suddenly I wasn’t alone. Singing this song together, knowing what it means to all of us, has been powerful.”

Every amount helps fund the fight. If you’re feeling inspired and would like to fundraise for Brain Tumour Research, visit our website to get started: www.braintumourresearch.org/ fundraise/get-fundraising

Brain tumours are indiscriminate; they can affect anyone at any age Your support will help fund vital campaigning and research
Leaving a legacy will help us get closer to finding a cure for all types of this devastating disease.
It’s never too early to think about drawing up a will –as 22-year-old Naomi Savage has recently done.
Naomi explained: “Buying a home with my boyfriend and taking on a mortgage prompted me to make a will – you never know what’s around the corner.
“Having been diagnosed with an ependymoma at the age of four and undergoing three craniotomies and 13 cycles of chemotherapy, I feel I’m one of the lucky ones, albeit I’m partially sighted and unable to drive.
“More children die from brain tumours than any other cancer, including leukaemia, so I want my gift to Brain Tumour Research to make a lasting difference so that having a brain tumour is no longer seen as a potential death sentence.”
We’ve partnered with Octopus Legacy so that you can have a simple will written or updated for free. There is no obligation to leave a gift to the Charity but if you did, it could be transformational, bringing hope to the thousands affected every year.

For more information, email: legacy@braintumourresearch.org

The next big day in our calendar – Walk of Hope on Saturday 27th September – is just around the corner. And it’s not too late to sign up to one of our six flagship walks or organise your own wherever you are.
Register for a flagship Walk of Hope and, in solidarity with our community, join the thousands of supporters all stepping out to help find a cure. Choose from:
• Wardown Park in Luton
• Brockwell Park, Herne Hill, London
• Strathclyde Country Park, Motherwell
• Torpoint in Cornwall
• Elvaston Castle in Derbyshire
• The New Forest, Hampshire

Check out our website to learn more, including distance and which walks offer food and drink, music or entertainment. Well-behaved dogs on a lead are welcome and most walks are pushchair or wheelchair accessible. Or team up with family, friends and colleagues to organise your own Walk of Hope!

Register NOW and put your best foot forward: www.walk-of-hope.org
Mark this year’s walk in your diary!
Saturday 27th



Following incredible collaborative work, the Rare Cancers Bill –introduced by Dr Scott Arthur, MP for Edinburgh South West – passed its third reading in the House of Commons, in July.
From the first conversation between the Charity and Dr Arthur at the Labour Party Conference to this landmark moment, we proudly stood alongside Dr Arthur, supporting his work from the outset. And the campaigning efforts of our entire community have been pivotal in pushing this Bill – which has the potential to transform thousands of lives – forward.
The Rare Cancers Bill could require Government to:
• Appoint a named individual responsible for overseeing the delivery of research into rare cancer treatments
• Review the Orphan Drug Regulations, with respect to rare cancer treatments
• Ensure that patients can be easily contacted about relevant research and clinical trials, thereby improving access to trials and the quality of trials in the UK
The Bill now passes for scrutiny in the House of Lords. If passed and made law, it will become the Rare Cancers Act, potentially transforming the experience of those diagnosed with rare cancers.
Like so many of our supporters, Dr Arthur was driven to make a difference by his personal pain, having lost his father-in-law, Ivor Hutchison, to a brain tumour, aged 76. During the Labour Party Conference in the Autumn of 2024, he spoke to us about this at a fringe event hosted by the Chair of the All-Party Parliamentary Group on Brain Tumours (APPGBT), Dame Siobhain McDonagh. Our conversations continued in the months that followed, leading to Brain Tumour Research playing a key role in the development of the Bill.

Our Head of Stakeholders Relations, Hugh Adams, said: “For Brain Tumour Research to have been a part of this from the very beginning, and to have had direct input into potential legislation that will make a real difference for brain tumour patients, fills me with enormous pride.
“This feels like the most impactful and important piece of campaigning work in our Charity’s 16-year history.”

Left: Thomas Brayford, Policy and Public Affairs Manager, Dr Scott Arthur, and Hugh Adams, Head of Stakeholder Relations
Below: Dr Scott Arthur and Dame Siobhain McDonagh
To stay up to date with all the latest campaigning and other news from Brain Tumour Research, subscribe to receive our weekly email newsletter: www.braintumourresearch.org/subscribe or scan the QR code to sign up

A mum’s tireless campaigning saw a milestone moment when the Prime Minister pledged his support for “life-saving” research in the House of Commons.
Laura Kurtul became a brain tumour campaigner after losing her only child, Taylan, to the disease when he was just six. Her efforts were rewarded when Sir Keir Starmer promised Laura a meeting with Health Minister, Ashley Dalton MP after her local MP, Alberto Costa, raised her case during Prime Minister’s Questions (PMQs).
During that meeting, the Minister promised to work with Brain Tumour Research and other charities to unblock barriers to research funding. Ms Dalton later echoed this promise at a meeting of the All-Party Parliamentary Group on Brain Tumours (APPGBT), with a further commitment to:
• Review the panels that oversee research proposals
• Improve public awareness around clinical trials
• Work with charities to improve trial participation
Above: Taylan Kurtul
Below: Alberto Costa



“Ashley is committed to ensuring Government funding is unlocked,” said Laura. “We feel hopeful we will create change together and spare other families from going through this heartache.”
Your voices will help us drive change. To campaign with us, visit: www.braintumourresearch.org/ campaigning/campaign-with-us


We’re calling on the Scottish Government to act to ensure brain tumour patients have access to world-class care.
Clinicians, researchers, patients and charity advocates stood united in delivering the message during a meeting of the Cross-Party Group (CPG) on Brain Tumours – for which Brain Tumour Research holds the secretariat.
Sharing their lived experiences, patients helped shine a spotlight on serious issues affecting them, with one campaigner describing his battle to access vorasidenib, a new drug available in some Scottish regions but not others. “It’s postcode prescribing,” he said. “We need leadership to fix this national lottery.”
Alongside the need to eliminate postcode-based disparities in drug access, the group further identified key priorities to combat the challenges faced by patients, including the need for equitable access to genomic testing and improved access to clinical trials.
The message was clear: Scotland has the expertise and the tools, but red tape is preventing progress.
Stay up to date with our campaigning across the UK on our website: www.braintumourresearch.org/ campaigning
We are influencing the Government and larger cancer charities to invest more in brain tumour research nationally
Together we will find a cure
Thomas Brayford, our Policy and Public Affairs Manager, said: “Standing alongside our partners in Scotland, we’re urging the Scottish Government to cut through the bureaucracy, back our experts and make sure every brain tumour patient in Scotland gets equal access to the tests, treatments and trials they deserve.”

Thomas Brayford and Convenor of the CPG, Beatrice Wishart MSP




Army
Here we celebrate some amazing achievements in the quest to find a cure.

Katie Smith has celebrated reaching a milestone birthday, after being given a 50/50 chance of making it to the age of 40, with a year of fundraising challenges. Additionally, Katie marked her 10 wedding anniversary
The generosity of those mourning his basketball-loving friend Andi Peel, helped Ross Bland raise a remarkable £5,000 through an epic charity match.
Committed fundraiser
Ella’s Army

Grandad Jack Penrose and 16 friends put the pedal to the metal in a 13-hour spinathon extravaganza in memory of 13-year-old granddaughter Ella, raising more than £3,400




singing and dancing as a tribute to his wife Elly, who always loved a party. Along with a race night coordinated by Elly’s daughter Laura Davie, and her son Peter Monaghan taking on our 88 Squats a Day challenge, more than £6,800 has been added to the pot this year.
In Kev’s Memory
Ges stepped up to mark his brother Kev O’Mahoney’s 60th birthday, accompanied by loyal friends, with an 80km Race Across Wales hike, totting up an impressive sum of more than £3,200



Laura meets the

Tay’s Tribe
Tay’s mum Laura Kurtul and friends dreamt up a fantastic fundraising festival for kids, which included visits from the Gruffalo Zack George (aka Gladiator, Steel) as well as a foam party, zoogie boogie disco, circus school and face painting, including obligatory festive glitter. The icing on the cake was more than raised in the fight to find a cure.

Family and friends conquered Snowdon’s summit to mark the fourth anniversary of losing Ria Melvin, as well as to remember Ryan Hughes, also lost to a brain tumour, adding almost £4,000 to this group’s fundraising total.
Thanks to a terrific trio, all affected by brain tumour loss, more than £4,000 has been raised for research. Josh’s brother Thomas Beresford-Smart, along with his cousin Imogen Keites, who lost her grandad David, and her boyfriend Nathan White, who lost his sister Debbie, were all proud medal-winners at the end of the Manchester Marathon.



www.braintumourresearch.org/pages/ about-our-fundraising-groups
A round-up of news and forthcoming events from our Member Charity family.


Carole Hughes was honoured at the Chelsea Flower Show. TV presenter Angelica Bell and actor Joanna Lumley surprised Carole by naming a beautiful gladioli after her daughter Anna, lost to a brain tumour. The emotional tribute was featured on the BBC’s The One Show, recognising Carole and her husband Rob’s incredible work.
This September, Brainwaves NI welcomes two new PhD researchers, Francesco and Katie, to work alongside the three student researchers (pictured below) it already funds at Queen’s University Belfast and to strengthen the Charity’s mission to advance brain tumour research in


Supporters starting the annual Norfolk Family Walk


The Charity, which focuses on low-grade brain tumours, is holding its 19th much-loved Norfolk Family Walk on 21st September 2025, setting out from the Holkham Hall estate near to Wells-next-the-Sea, with a range of distances starting from one mile up to 10 miles.



Congratulations to two dedicated researchers: Dr Phoebe McCrorie, who has been awarded the prestigious British Neuro-Oncology Society (BNOS) Young Investigator of the Year Award for 2025, and Dr Hannah Jackson, who has been recognised with the Brain Research UK Fellowship



Offering work experience to two Year 10 students inspired a generous payback. Oscar and Elsie organised a Quiz ‘n’ Chips night, which raised vital funds for the Charity. Meanwhile, Finnbar’s Force has set up monthly family support groups and a special dads’ group, in partnership with Young Lives vs Cancer, for those affected by brain tumours and cancer generally.

Enterprising Brownie Guide Eloise Hoyes decided to take on her Charity Badge, inspired by James Campling, who was lost to a glioblastoma in 2018 – a friend of her dad’s. The coffee morning she organised, raised an amazing sum of well over £500.
Join our family of Member Charities


A stand at the Great Yorkshire Show sponsored by Calbee and Seabrook Crisps, with volunteers from Leeds Building Society, Calbee and We Are In Business, raised more than £1,000 and helped raise awareness. Meanwhile, the Chairman of North Yorkshire Council, Roberta Swiers, who named YBTC as her Charity of the Year, has already raised more than £6,000
We’re building a united front of brain tumour charities across the UK because together we are stronger.
To find out about the benefits of collaborating as a Member Charity, please contact Eleni, our Head of Philanthropy & Partnerships, via email: eleni.paschou@braintumourresearch.org
Supporting Brain Tumour Research as a Corporate Partner offers a unique opportunity to play a pivotal part in accelerating research – and there are plenty of ways to get involved. You could make an impact with our volunteering opportunities, support us through Payroll Giving, sponsor an event, or nominate us as your Charity of the Year.
We’re thrilled to welcome competition platform GoGoVox as our newest Partner, who joined in July as part of a two-year pledge.
Founder and Director, Mark Beeny, said: “At GoGo Vox, we believe in using our platform, not just to entertain, but to empower. Our connection to this vital cause is personal and heartfelt, rooted in the story of our dear friend Penny Church, who lost her son, Finlay, to a glioblastoma in 2014.”

GoGoVox launched the partnership with a fundraising competition, fronted by freestyle footballer Ben Nuttall, where entrants were given the chance to win a pair of signed Adidas boots. Over the coming 24 months, the team will continue to host and take part in a variety of awareness campaigns and promotional initiatives, to drive donations.
The company’s passion, reach and commitment to making a difference will be invaluable as we continue to campaign for better outcomes for brain tumour patients and their families.


Could your workplace support our vital work? Contact our Corporate Partnerships Manager Aimee Clarke to find out more: aimee.clarke@braintumourrsearch.org

The festive season is an extremely busy time so, to help you get prepped for the big day, we’ve cultivated a range of Christmas cards, gift wrap and tags to help you embrace your loved ones this December. And we’re offering other seasonal merchandise too, including Advent calendars, money wallets and Santa letter kits.
Proceeds from sales of our Christmas cards and merchandise will support our vital work to fund, and campaign for, research into brain tumours.






Packs of 10 Christmas cards
Check out our full range online by scanning the QR code or visit: www.braintumourresearch.org/ collections/christmas-cards



Prefer to purchase your cards in person? Visit your local pop-up charity Christmas cards shops, run by Cards for Good Causes, and buy cards supporting Brain Tumour Research. Find your closest pop-up online: www.cardsforcharity.co.uk/find-a-shop

Michael Appleyard
Howard Banks
Russell Barton
Beryl Bathurst
Pamela Frances Beatrice Beckett
Doris Beckinsale
Amy Bell
Ivan Bevan
Jez Bevan
David Bilton
Joan Elizabeth Bishop
Jacqueline Blowers
Bernard Braithwaite
James Brown
Steven Brown
Stewart Bryson
Allan Burridge
Andrew Burton
Arthur Chalcraft
Glenn Colmer
Janet Comley
Violet Craven
Neil Danziger
Marc Davis
Teresa Davis
Emilia Distefano
Gardner Dixon
Ronnie Duxbury-Macleod
Michael Feeney
Stu Fendley
Peter Fitch
Brian Gower
Izabella Halina Joanna Gray
Alban Hall
Terence Hall
Steve Harris
From all of us at Brain Tumour Research, our love and thoughts are with all of you who inspire us and continue to support us in memory of your loved ones and colleagues, year after year.
Lynda Hart
Rosalie Jean Howell
Pam Hughes
Patricia Humphreys
Ann James
Sydney David Jewell
Wadaw Jezierski
Stuart Johnson
Nesta Jones
Sarah Jopling
John Kassim
Anne Maria Khan
Paul King
Terry King

Michael Large
Delroy Hugh Latham
David Lee
Barry Lewis
We thought of you with love today, but that is nothing new. We thought about you yesterday, and days before that too. You are forever in our hearts.
Robert Lowe
John Luffman
Anthony Lynch
Graeme McAllen
Sandra McDonough
Robert McLachlan
James Medland
Steven Meech
Debbie Morris
Robert Morris
Noreen Murray
Anne Filumena Owen
Yvonne Piddington
Brian Postlethwaite
Christine Preece
Sandra Prescott
Pauline Prior
Timothy Rayment
Ken Reynolds
Arthur Rhodes
Allan Rivans
Alan Salter
John Shand
Christine Shipp
John Sinden
Paul Smith
Antony Soanes
Frank Stanford
Hedley Stephens
James Stephens
Gerald Stevens
Patrick Stevenson
Kathleen Sturgeon
Bradley Sweeney
Carol Sykes
William Thompson
Katrina Thorburn
Lucinda Turner
Lionel Vine
Sarah Walker
Carol Warr
Christopher Williams
Susan Corten Willis
Winifred Wooledge
Margaret Wright
Sylvia Wright
Peter Young

Loved ones here include those lost to a brain tumour for whom we received funeral donations between January and June 2025.

£10,000